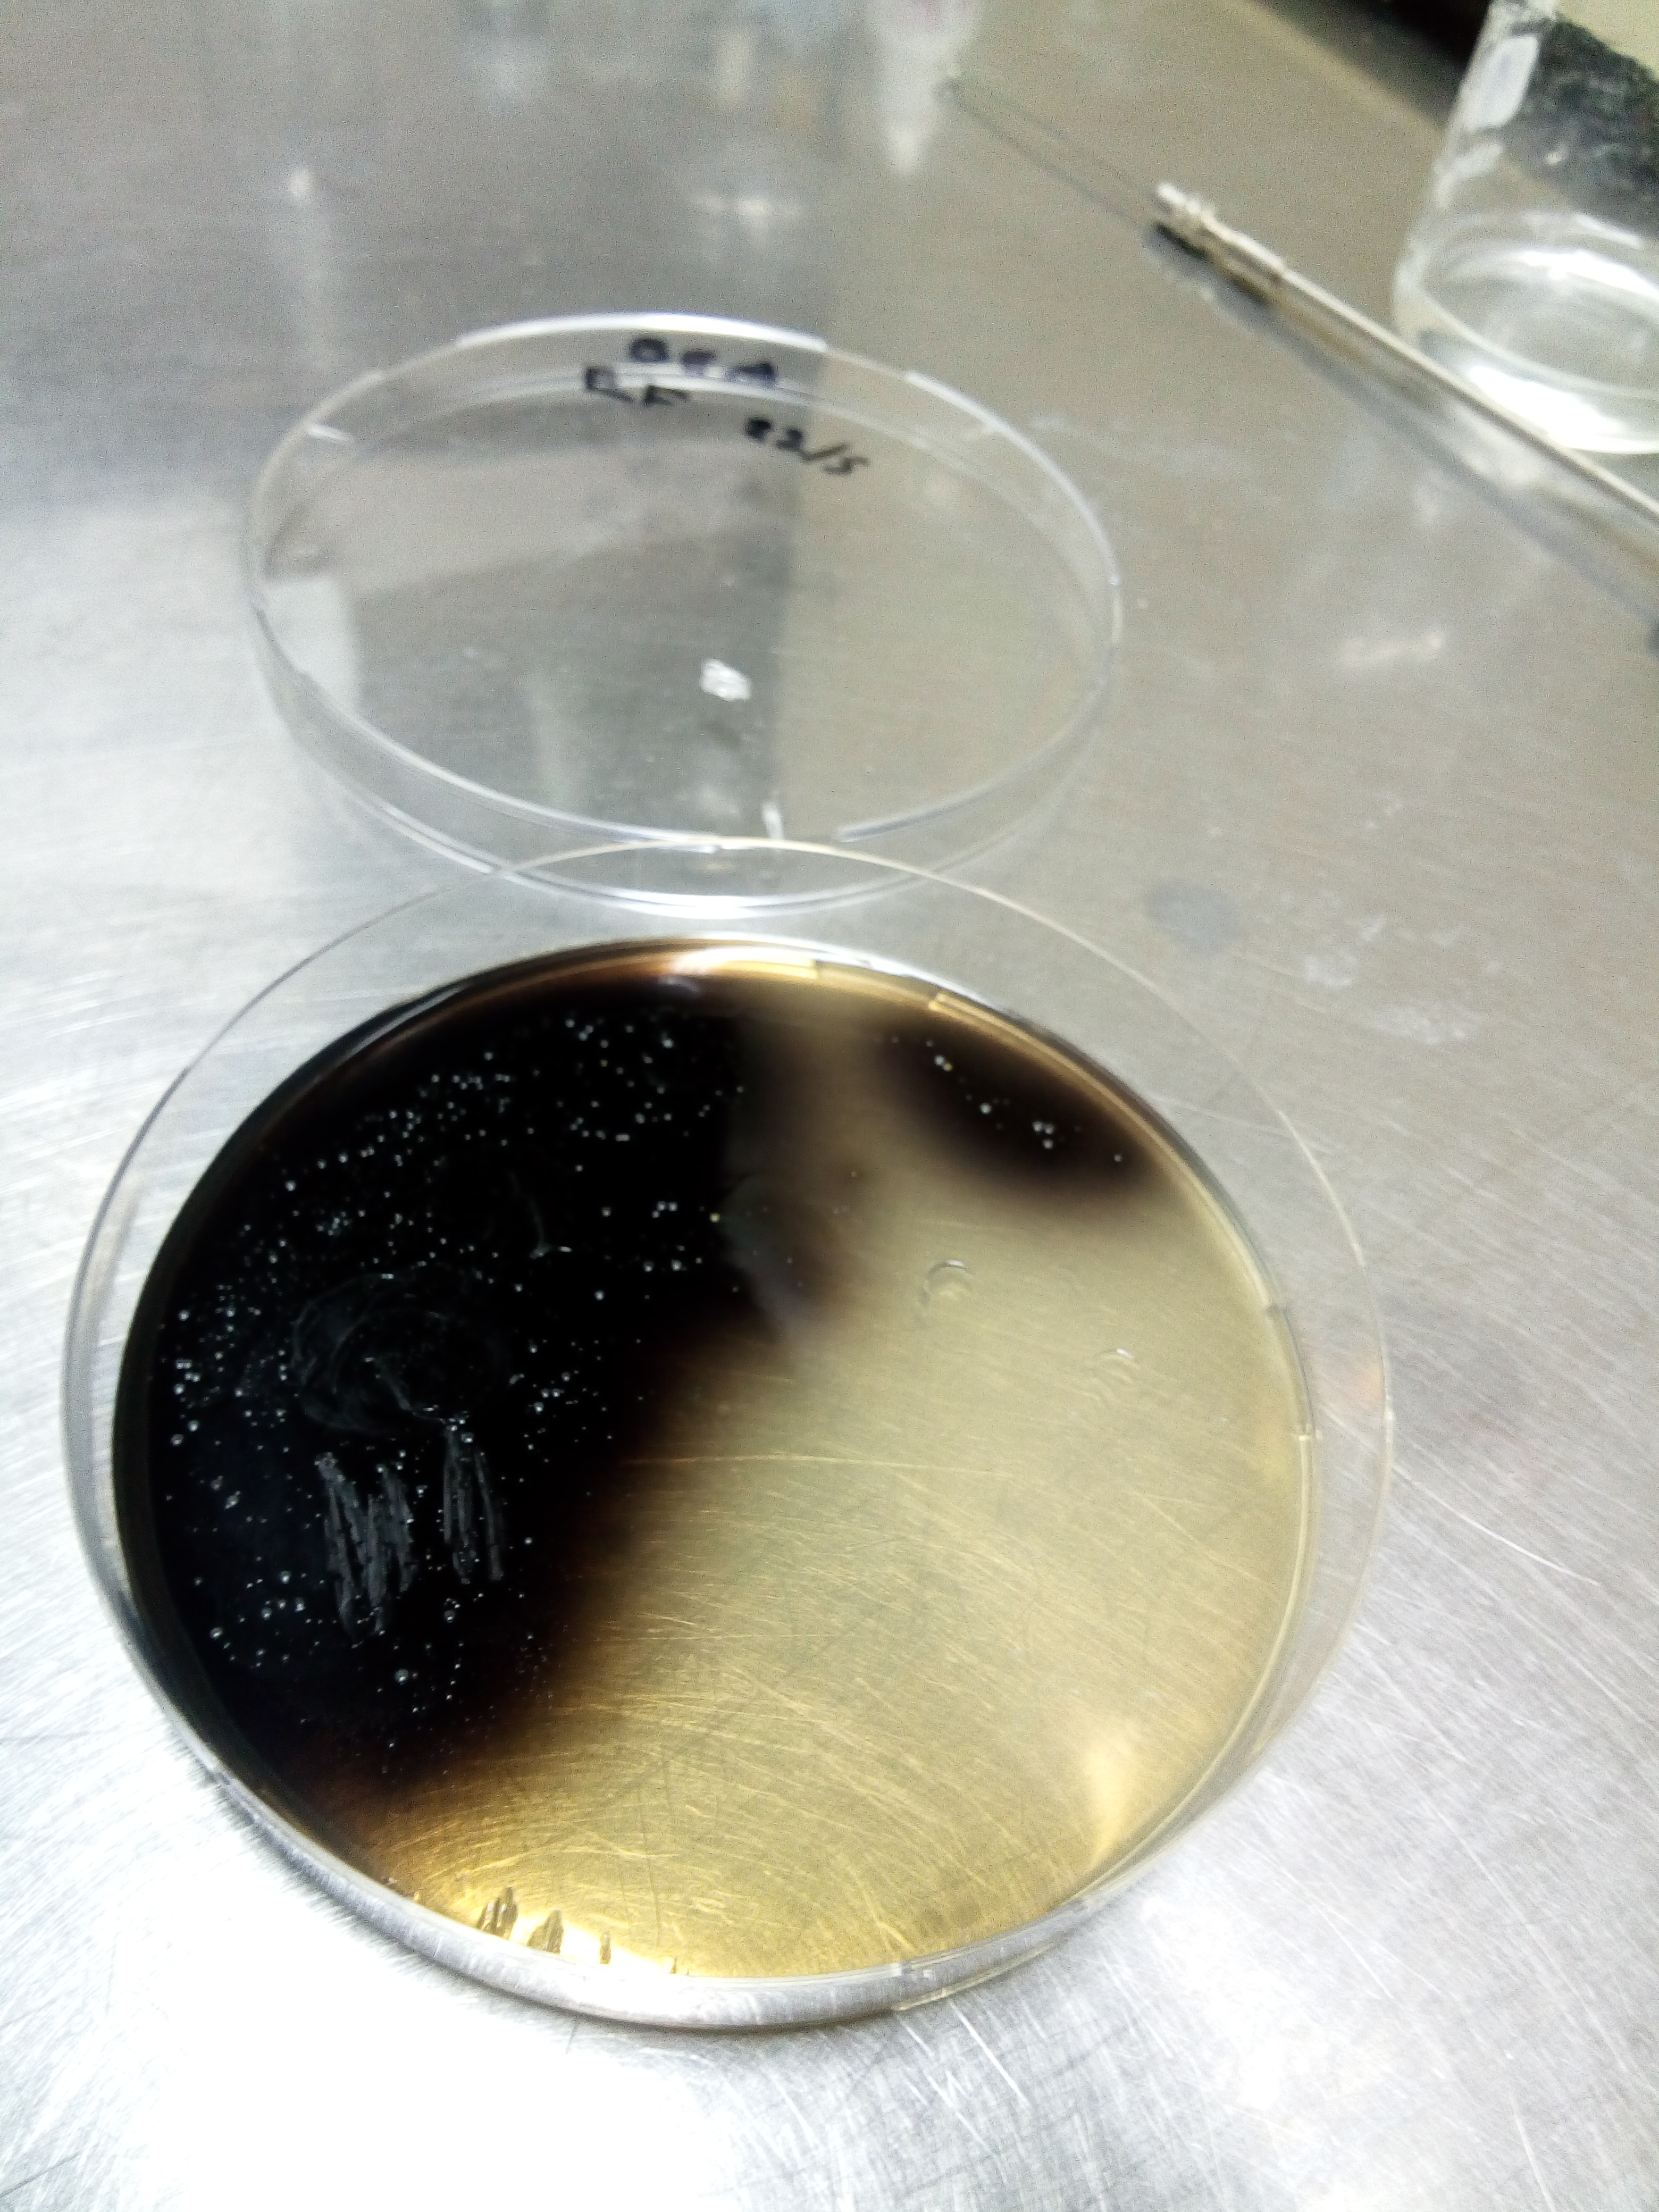

ANÁLISIS MICROBIOLÓGICO DE AGUA Y ALIMENTO
(para consumo humano y animal)
DESCRIPCIÓN
Se realiza (desde el año 2000) la evaluación microbiológica de diversos alimentos de consumo humano y animal, y del agua; considerando su aptitud para su venta, consumo directo, etc. tanto en particulares como en fábricas de alimentos.
Se analizan los efluentes vertidos y también se hacen controles microbiológicos de equipamientos, mesadas, ambientes y de manipuladores de alimentos.
La aptitud del agua y los alimentos se basan en los requisitos microbiológicos del Código Alimentario Argentino y las metodologías utilizadas son normativas internacionales APHA (American Public Health Association).
EQUIPAMIENTO
Estufas de cultivo, vortex, agitadores magnéticos, shaker, balanzas, stomacher, autoclave.
RESPONSABLES
Dra. Anahí Tabera
Profesor Adjunto Docente Responsable del Curso de Microbiología de los Alimentos de la Lic. en Tecnología de los Alimentos y del Curso de Microbiología Alimentaria y Análisis de Alimentos de la Orientación en Tecnología de los Alimentos de Medicina Veterinaria.
Dra. Juliana González
Auxiliar de docencia, participa en el Laboratorio de Servicios. Ayudante de primera, comparte las dos materias mencionadas.
Se realiza (desde el año 2000) la evaluación microbiológica de diversos alimentos de consumo humano y animal, y del agua; considerando su aptitud para su venta, consumo directo, etc. tanto en particulares como en fábricas de alimentos.
Se analizan los efluentes vertidos y también se hacen controles microbiológicos de equipamientos, mesadas, ambientes y de manipuladores de alimentos.
La aptitud del agua y los alimentos se basan en los requisitos microbiológicos del Código Alimentario Argentino y las metodologías utilizadas son normativas internacionales APHA (American Public Health Association).
EQUIPAMIENTO
Estufas de cultivo, vortex, agitadores magnéticos, shaker, balanzas, stomacher, autoclave.
RESPONSABLES
Dra. Anahí Tabera
Profesor Adjunto Docente Responsable del Curso de Microbiología de los Alimentos de la Lic. en Tecnología de los Alimentos y del Curso de Microbiología Alimentaria y Análisis de Alimentos de la Orientación en Tecnología de los Alimentos de Medicina Veterinaria.
Dra. Juliana González
Auxiliar de docencia, participa en el Laboratorio de Servicios. Ayudante de primera, comparte las dos materias mencionadas.